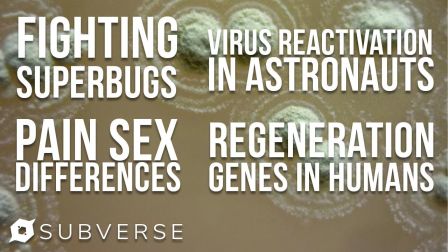

Subverse is your source for reliable news coverage, our stories often go underreported. We don't add spin to our analysis, allowing you to think for yourself.
New Videos Monday-Thursday!
Subscribe to keep up with our videos and enable notifications so stay up to date with our coverage.

12:38
Social Media Combats Chinese Propaganda about Hong Kong Protests | Subverse News

10:01
Congressmen Take Action Against Chinese Communist Party & Hong Kong Police | Subverse News

8:55
Protesters March on Albany for New York to Open for Business | Subverse News

10:56
Protests as Trump Becomes First President to Speak at Veteran's Day Parade | Subverse News

10:55
Protesters Demand Trump Impeachment Outside Hershey, PA Rally | Subverse News

22:21
Russian Girls: A Look at Contemporary Womanhood | Subverse News

12:19
Democrats Renew Patriot Act Surveillance, DoD Fails Audit, House Passes Legalization | Subverse News

12:28
Arrests Made at 'Storm Area 51' after US Navy Confirms Video of Aerial Phenomenon | Subverse News

10:08
Internet's Inventor WARNS Of Greedy Companies and Government Control

10:35
Citywide Clashes in Hong Kong Against Government on Chinese National Day | Subverse News

10:19
Millions of Acres of Farmland Going Unplanted from Heavy Flooding

13:37
Union Vote Defeated Again, UAW Tries to Gain Foothold in Southern US

16:47
The Growing Threat of Food Shortages Explained by Crawfish and Rice Farmers in China, Texas | SCNR

9:52
Iranians Stand Against Morality Police, Inmate Rescues Toddler, UPS Stops Car Chase, & More

14:18
Trump's Visit to Support Police in Chicago Ignites Protests | Subverse News

10:42
Big Tech's Battle for "War Cloud" Goes Critical | Subverse News
10:17
Fighting Superbugs, Sex Differences in Medicine, Scientific Breakthroughs

12:32
Auto Workers STRIKE, Demand Higher Wages, GM Refuses to Back Down | Subverse News